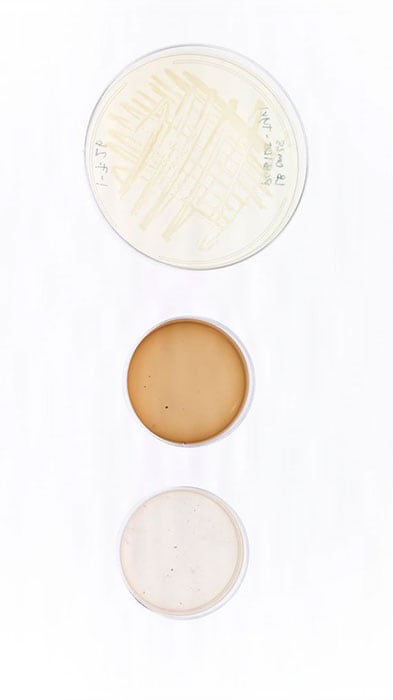
Three petri dishes containing bacterial cultures on display in Washington D.C.

Why Growing Useful Bacteria in Space is Harder Than It Looks

Tiffany Hennessa (left), U.S. Naval Research Laboratory (NRL) research biologist, and Zheng Wang, NRL research biologist, analyze a microbial sample in Washington, D.C. Scientists at NRL sent microbial samples to the ISS to investigate how microgravity affects microbial metabolism and biomaterial production.
Media Credit: U.S. Navy photo by Sarah Peterson
March 30, 2026 • By Stephenie Livingston, Senior Staff Writer
Place a living thing in a hostile environment and its usual biological cycles unravel, giving way to survival and change. A desert plant curls inward to save water. A deep-sea fish gains the ability to glow. In the ruins of Chornobyl, site of the 1986 nuclear disaster, blackened fungi creep across reactor walls, absorbing radiation that should kill them. And in space, microbes—among the smallest organisms ever sent beyond Earth—redirect their energy, dialing down routine cellular work and ramping up intricate survival responses to withstand microgravityThe condition of perceived weightlessness created when an object is in free fall, for example when an object is in orbital motion. Microgravity alters many observable phenomena within the physical and life sciences, allowing scientists to study things in ways not possible on Earth. The International Space Station provides access to a persistent microgravity environment..
Those extremes, whether radiation-soaked ruins or the weightless conditions of space, form the backdrop of biologist Zheng Wang’s research. At the U.S. Naval Research Laboratory (NRL), he explores how life responds when pushed to its limits and whether the intricate stress responses that sustain organisms can also power new applications.
For years, scientists have imagined using microbes as tiny factories beyond Earth that grow food, medicines, and materials on demand for astronauts traveling far from home. One material has been especially intriguing: melanin, the pigment best known for coloring human skin, hair, and eyes. Beyond its role in appearance, melanin can also absorb ionizing radiation, dissipate energy, neutralize reactive chemicals, and remain stable across extreme temperatures. In microbes, melanin functions as a protective barrier against environmental stress, with antioxidant activity, environmental remediation capacity, and thermal regulatory properties—features that may help organisms survive in space.

Tiffany Hennessa (left), U.S. Naval Research Laboratory (NRL) research biologist, and Zheng Wang, NRL research biologist, analyze a microbial sample in Washington, D.C.
Media Credit: U.S. Navy photo by Sarah Peterson
That protective power is what drew Wang’s team to melanin as a candidate for space biomanufacturing. To produce it efficiently, the researchers turned to Escherichia coli, a widely used bacterium that is easy to reprogram.
Because E. coli does not make melanin on its own, Wang and his NRL team engineered it to convert a common amino acid into the dark pigment, which can absorb radiation and sustain microbial growth. “Our long-term goal is to make materials where they’re needed, in space,” he says, “rather than transporting everything from Earth.”
But when those melanin-producing microbes reached the International Space Station (ISSInternational Space Station), microgravity began interfering. The investigation, part of the Melanized Microbes for Multiple Uses in Space Project (MELSP) sponsored by the ISS National Laboratory®, launched in November 2023 to see whether engineered microbes could reliably produce protective materials in space. Wang and his team discussed their findings in a 2025 study published in npj Microgravity. They found that while the bacteria could still synthesize melanin in space, microgravity interfered with how cells absorbed nutrients, handled stress, and allocated metabolic resources, reducing output.
“The biggest takeaway is that if we want to manufacture materials using microbes in space, we have to solve the issue of how nutrients get into cells,” said Wang, principal investigator of MELSP and a research biologist at NRL’s Center for Bio/Molecular Science and Engineering. “Without that, the cells become stressed and stop functioning in the way we expect.”
A Reality Check for Space Factories
Radiation is one of the most persistent hazards of long-duration spaceflight. By manufacturing melanin in space, microbes could one day help protect astronauts or equipment and reduce the need to launch heavy shielding from Earth. On the ground, producing melanin is relatively straightforward. Scientists use E. coli bacteria engineered to convert the amino acid tyrosine into melanin pigment. In flasks and fermenters on Earth, the bacteria darken predictably, turning petri dishes dark brown. But the space samples looked odd.
“In space, it looked more like coffee with milk,” says Wang.
At first, the latte-like appearance of the samples made the team suspect a genetic failure. Perhaps the engineered bacteria weren’t turning on the right genes in space. But further analyses showed the genetic machinery was still working, including tyrosinase, the enzyme that drives melanin production in the engineered E. coli.
Microbial samples for the experiment sit on display in Washington, D.C.
Media Credit: U.S. Navy photo by Sarah Peterson
“So the problem wasn’t the enzyme,” says Wang, “It was everything happening around the cells.”
Chemical measurements pointed to the culprit. Large amounts of the melanin precursor, tyrosine, lingered unused in the growth medium after spaceflight. The cells couldn’t move the material inside. “Without gravity,” Wang explained, “nutrient transport just didn’t work the same way.”
On Earth, gravity helps fluids mix and circulate, constantly bringing nutrients into contact with cells. In microgravity, that sort of churning disappears. Cells that evolved under gravity’s steady pull suddenly must function in a world without it. Under those stressful conditions, the bacteria “shifted their energy toward protecting themselves instead of making melanin,” Wang said. Technically, they still could produce melanin, but they didn’t have the energy.
To isolate the effects of microgravity on E. coli, the team collaborated with microbiologist Cheryl Nickerson and her laboratory at Arizona State University to recreate aspects of the space-based microgravity environment on Earth using a Rotating Wall Vessel (RWV) bioreactor. This NASA-developed system cultures cells under low-fluid-shear conditions that mimic microgravity.
When Nickerson and her team ran experiments in the RWV using the same E. coli strain used on the ISS, they observed the same pattern. The bacteria produced less melanin, showed disrupted metabolism, and had lower cell survival.
She emphasized that “as with any model, the RWV is not perfect and does not completely reproduce the full extent of environmental factors associated with spaceflight.”
That limitation, she added, is why “it is necessary to fly biological spaceflight experiments for a more complete understanding.”
The takeaway, Wang says, is that engineering microbes for space will require more than genetic tweaks. Future efforts may need to focus on designing growth environments, such as bioreactors that actively move nutrients, manage stress, and compensate for the absence of gravity so bacteria can focus on production rather than just fighting for their lives.
Why Fungi May Fare Better
Alongside bacteria, the team also sent fungi to the space station. Fungi tend to survive where other organisms falter. They are more complex than bacteria, sturdier than many animal cells, and unusually comfortable in environments that would wipe out most life. If space biology is a stress test, fungi are the organisms you send when you want to see what still works after everything else breaks.
The team’s fungal samples are still being analyzed, but the initial results are striking. All of the samples survived spaceflight, and, unlike the engineered bacteria, the fungi continued to produce a steady amount of melanin.
That durability is what draws researchers like Tiffany Hennessa, a research biologist in NRL’s Laboratory for Molecular Interfaces and co-principal investigator of MELSP, to fungi in the first place. “Fungi are incredibly tough,” she said. “Even after extreme freezing or drying, they’re able to recover and grow.”
What interests Hennessa most, though, is how fungi change when survival becomes the only priority. Under stress in space, cells sometimes activate biochemical pathways they rarely use on Earth. In doing so, they can produce molecules that never appear under gentler conditions.
Some of the fungal strains sent to the space station were deliberately impaired. A few were engineered to be unable to repair DNA damage. Others were stripped of melanin’s usual protections. If those organisms persist anyway, Hennessa wants to know what compensates for it. Not exactly what keeps them alive, but what new chemistry that pressure forces them to invent.
“We’re interested in whether space pushes organisms to produce molecules beyond melanin,” she said. “We want to know whether the same stress responses that keep them alive can be redirected toward producing something useful to humanity.”

Tiffany Hennessa (left), U.S. Naval Research Laboratory (NRL) research biologist, and Zheng Wang, NRL research biologist, analyze a microbial sample in Washington, D.C.
Media Credit: U.S. Navy photo by Sarah Peterson
Lessons From Hostile Worlds
Long before Wang sent microbes to the space station, he was thinking about places where life is not supposed to survive. One of them was Chornobyl.
In the years after the nuclear accident, scientists surveying the ruins found something unexpected. Communities of bacteria and fungi were thriving in radiation levels harmful to most life. Many of them shared a strange trait. They were dark, saturated with melanin. The same pigment that gives human skin its color appeared to act more like armor than sunscreen in an extreme situation. Even stranger, some organisms seemed to benefit from radiation exposure, with melanin playing a role that researchers have cautiously likened to a radiation-assisted form of metabolism.

Microbial growth spreads across the damp interior of an abandoned building in the Chornobyl exclusion zone.
Media Credit: Wendelin Jacober
That observation stayed with Wang. If melanin-producing microbes could survive in one of the most irradiated environments on Earth, he wondered what else they might endure, and what the pigment itself might be capable of doing.
The question followed him to another extreme: the icy skies above Antarctica. Wang’s team sent fungal samples aloft on a high-altitude balloon, into thin air where ultraviolet radiation is so intense it can disintegrate DNA and kill unprotected microbes outright. They are currently analyzing data from this investigation to understand the roles of melanin and DNA repair in such a harsh environment.
By the time Wang turned his attention to space, the pattern was clear. But space would test Earth’s biology against something a bit different. Microgravity does not burn or poison cells. It is a unique stressor that reprograms cellular and molecular mechanisms in unexpected ways, allowing cells to survive under spaceflight conditions.
The lesson, Wang says, is that space is a novel environment and does not always test biology in obvious ways. It exposes which survival strategies are fundamental on Earth and which may only work under its gravity. What the microbes onboard the space station ultimately demonstrated is that biological usefulness depends on context. Traits that serve organisms well under Earth’s gravity do not always translate to microgravity, where cells recalibrate internal pathways to meet unfamiliar demands.
That may be the most useful result of all. The experiment served as a reminder that the cellular adaptations that prevail in space are often very different from what performs best for the same organism on Earth. For anyone envisioning biology as infrastructure beyond the planet, Wang says, that distinction matters. And if Earth grows more extreme, the organisms that already survive—or even thrive—under extremes are worth studying. They reveal how life keeps going when conditions turn hostile.
Want to share this feature with a colleague or save it for later? Download a PDF version of this feature.

Amelia Williamson Smith, Upward Managing Editor
Letter From the Editor
Ten years ago, I sat at my computer brainstorming how best to share the amazing science enabled by the ISS National Lab. It was then that Upward was born.
We chose the magazine’s name for many reasons. We look upward to the ISS—our nation’s only orbiting laboratory—to solve some of humanity’s greatest challenges and to create things not possible on the ground. We endeavor upward in our pursuit of advancing science and technology in space to improve life on Earth. And we raise our aspirations upward beyond the ISS to a future where commercial space stations operate in a robust low Earth orbit(Abbreviation: LEO) The orbit around the Earth that extends up to an altitude of 2,000 km (1,200 miles) from Earth’s surface. The International Space Station’s orbit is in LEO, at an altitude of approximately 250 miles. (LEO) economy.
I hope you enjoy this 10th anniversary edition, in which we highlight how the idea of manufacturing products in space for use on Earth is no longer confined to science fiction. Studies enabled by the ISS National Lab over the past decade have shown that not only is this vision possible—it’s right around the corner.
As we look ahead to this exciting future, we also take a moment to look back on the road that brought us here. The ISS has served as an invaluable testbed for in-orbit production. It’s a place where companies can validate systems and facilities, refine and optimize production processes, and uncover ways to scale their manufacturing on future LEO platforms. It remains a critical step toward the next industrial revolution—in space.
I am so proud of how far Upward has come over the last 10 years and all the stories we’ve shared that showcase the value of conducting research and technology development in space. I am thankful for our amazing team that helped bring the idea of the magazine to life. And I am grateful to you, our readers, for joining us on this incredible journey of discovery. We hope you continue to follow along as we forever strive upward.